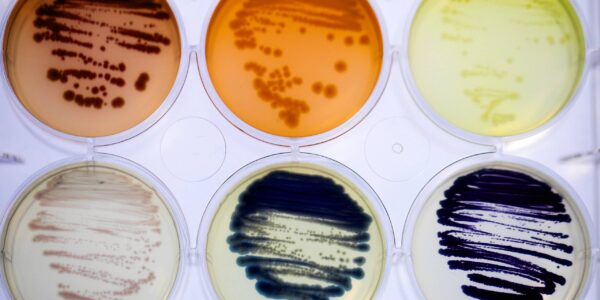

Cambridge, the University and its wider network has been great to Colorifix. Beyond just being where we started the company, the University and Cambridge Enterprise assisted us in preparing our first pitch for investment and has helped us through multiple funding rounds – including through their generous investment.
We’ve collaborated with multiple groups within the university on grants and have greatly benefited from the first-class research ongoing at the University of Cambridge. We greatly value their knowledge and expertise and will continue to work with the University, its research groups and Cambridge Enterprise towards the next steps in globalising uptake of our technology.
Dr Orr Yarkoni
Co-founder and Chief Executive Officer, Colorifix
Colorifix is pioneering the first entirely biological process to produce, deposit, and fix pigments onto textiles, leading a global movement to transform the fashion and textiles industry by drastically reducing the use of harsh chemicals, water, and energy.
The UK-based synthetic biotechnology company was co-founded in 2016 by University of Cambridge researchers, Professor Jim Ajioka and Dr Orr Yarkoni, who were driven by a mission for systemic change.
Traditional industrial dyeing consumes massive amounts of water, around five trillion litres per year, and releases over 70 toxic chemicals into freshwater systems. Colorifix’s synthetic biology approach leverages engineered microbes as tiny biological factories to create and transfer pigments directly onto fabrics. This holistic solution eliminates the use of harmful chemicals, resulting in an independently verified 80% reduction in chemicals and up to a 77% decrease in water consumption.
Supported early on by Cambridge Enterprise, Colorifix raised a £18 million Series B round in 2022, led by H&M Group’s corporate venturing arm. To accelerate global adoption, the company raised a further $18 million B2 round in 2025, led by Inter IKEA Group. This funding supports expansion across Europe and Asia, and has allowed the company to treble its team size and scale its operations. In 2023, Colorifix was recognized as a finalist in the prestigious Earthshot Prize for its contribution to building a waste-free world. With accelerating adoption among forward-thinking partners, the company aims to make sustainable dyeing the new standard across fashion and beyond.
Published:
Colorifix data
- University Affiliation
- University of Cambridge Spinout
- Funders
- Infrastructure accessed
- Industry sector
- Materials and chemicals
- Technology type
- Manufacturing
- Website
- www.colorifix.com